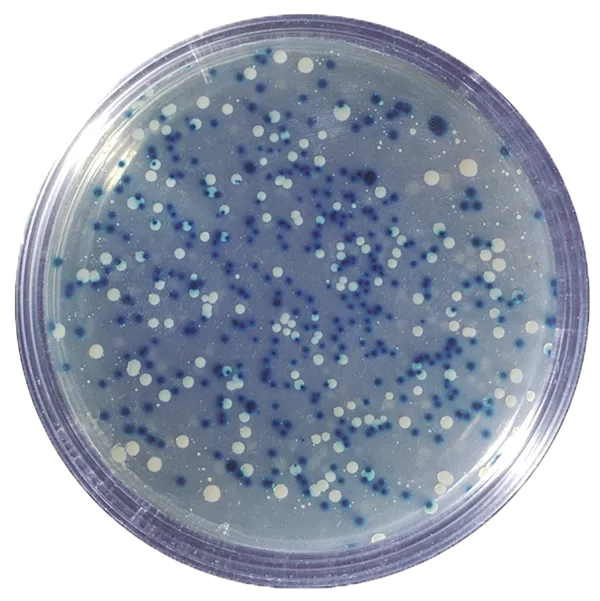
Blå/hvid kloning af DNA  (778300)

Varenr. 776016
Bakterier - Origami Organelles
48,00 DKKEksl. moms
Stort udvalg af biologiudstyr til undervisning og professionelt brug. Hos Frederiksen Scientific finder du mikroskoper, stereolupper, DNA-elektroforese, anatomimodeller, apparater, præparater og redskaber til botanik, zoologi og cellebiologi. Se udvalget her

Varenr. 776016
Bakterier - Origami Organelles
48,00 DKKEksl. moms

Varenr. 079120
Bakterier, serie af 25 præparater
2.495,00 DKKEksl. moms

Varenr. 572220
Bestikæske med hængslet låg, klar
50,00 DKKEksl. moms

Varenr. 779180
Bestrålede frø, radise
432,00 DKKEksl. moms

Varenr. 779185
Bestrålede frø, Wisconsin Fast Plant
160,00 DKKEksl. moms

Varenr. 076630
Biogasfremstilling, kasse, 3 x 500 mL flasker
503,00 DKKEksl. moms

Varenr. 079185
Bjergarter og mineraler, 10 forskellige præparater
3.137,00 DKKEksl. moms

Varenr. 776022
Bladstruktur - Origami Organelles
50,00 DKKEksl. moms

Varenr. 773530
Blodkredsløb, reliefmodel
2.334,00 DKKEksl. moms

Varenr. 780030
Blodlancetter
55,00 DKKEksl. moms

Varenr. 780037
Blodserum, Anti-A, 10 mL
130,00 DKKEksl. moms

Varenr. 780038
Blodserum, Anti-B, 10 mL
130,00 DKKEksl. moms

Varenr. 780036
Blodserum, Anti-D, 10 mL
270,00 DKKEksl. moms

Varenr. 780527
Blodtryks- og pulsmåler M7
1.576,00 DKKEksl. moms

Varenr. 780560
Blodtryks- og pulsmåler RS, håndled
628,00 DKKEksl. moms

Varenr. 780080
Blodtypesæt AB0-Rh, simuleret blod
813,00 DKK 699,00 DKKEksl. moms
Varenr. 778300
Blå/hvid kloning af DNA
1.995,00 DKKEksl. moms

Varenr. 076853
Blåfilter, Ø32 mm
19,00 DKKEksl. moms

Varenr. 800638
Bromthymolblåt-laktose-agar, pulver
41,00 DKKEksl. moms

Varenr. 778135
Brug af CRISPR til behandling af cystisk fibrose
1.051,00 DKKEksl. moms

Varenr. 078852
Celledeling, rod/løg, 25 præparater
201,00 DKK 170,00 DKKEksl. moms

Varenr. 067900
Centrifuge, Nuve, NF 200, 12 x 15 mL
7.500,00 DKK 7.125,00 DKKEksl. moms

Varenr. NL212155
Chlamydomonas, små biflagellate alger
91,00 DKKEksl. moms

Varenr. 779853
Chloramphenicol, discs til agar
94,00 DKKEksl. moms
Biologiudstyr til undervisning, laboratorier og forskning
Hos Frederiksen Scientific tilbyder vi et komplet udvalg af udstyr til biologi. Vores sortiment spænder bredt – fra undervisningsmaterialer til grundskole og gymnasier til avanceret laboratorieudstyr til universiteter, forskningsmiljøer og industri.
Uanset om du skal undervise i anatomi, analysere DNA eller udforske planter og dyr i felten, finder du hos os de rette redskaber til at gøre biologien levende og praktisk.
Udstyr til alle biologiens hovedområder
- Anatomi og fysiologi: Skeletter, torsoer, kranier og organmodeller, der giver en visuel forståelse af kroppens opbygning og funktion.
- Apparater: Laboratorieudstyr til målinger, analyser og biologiske eksperimenter.
- Cellebiologi: Redskaber og kits til at undersøge celler, væv og deres funktioner.
- DNA-elektroforese: Udstyr til molekylærbiologi og genetik – ideelt til undervisning og forskning.
- Mikrobiologi og mikropræparater: Mikroskoper, præparatsæt og redskaber til at studere bakterier, svampe og andre mikroorganismer.
- Mikroskoper og stereolupper: Fra undervisningsvenlige modeller til professionelle laboratoriemikroskoper.
- Botanik og zoologi: Bestemmelsesduge, indsamling, dyrkningsforsøg og modeller til at studere planter og dyr.
Biologi i undervisning og professionel praksis
Biologi spiller en central rolle i at forstå alt levende – fra cellens mindste strukturer til hele økosystemer. Med vores udstyr kan elever og forskere undersøge emner som celleprocesser, genetik, anatomi, fysiologi og biodiversitet.
For professionelle laboratorier og industrien tilbyder vi præcisionsudstyr til analyser, kvalitetssikring og forskning, hvor pålidelighed og høj kvalitet er afgørende.
Mange af vores biologiartikler egner sig også perfekt til privat brug – tag for eksempel fiskenet, lupper, vandkikkerter og kikkerter med på stranden, i skoven eller på tur i naturen, og gør oplevelserne endnu mere spændende.
Frederiksen Scientific – erfaring og kvalitet i mere end 70 år
Med over 70 års erfaring er vi blandt de førende leverandører af undervisnings- og laboratorieudstyr. Vores biologiudstyr er nøje udvalgt til at være robust, brugervenligt og velegnet til både læring, forskning og praktisk anvendelse.